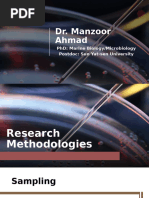

0% found this document useful (0 votes)
148 views62 pagesSampling Techniques Guide
This document discusses various sampling techniques used in surveys. It begins by defining key terms like sample, sampling frame, and population. It then outlines the ideal requirements of a sample and general steps in the sampling process. The document introduces two main categories of sampling techniques - probability sampling and non-probability sampling. It provides examples to illustrate different probability sampling methods like simple random sampling, systematic random sampling, stratified random sampling, cluster sampling, multiphase sampling, and multistage sampling. It also discusses some non-probability sampling techniques like quota sampling and purposive sampling.
Uploaded by
Vijay ChinthaCopyright
© © All Rights Reserved
We take content rights seriously. If you suspect this is your content, claim it here.
Available Formats
Download as PPTX, PDF, TXT or read online on Scribd
0% found this document useful (0 votes)
148 views62 pagesSampling Techniques Guide
This document discusses various sampling techniques used in surveys. It begins by defining key terms like sample, sampling frame, and population. It then outlines the ideal requirements of a sample and general steps in the sampling process. The document introduces two main categories of sampling techniques - probability sampling and non-probability sampling. It provides examples to illustrate different probability sampling methods like simple random sampling, systematic random sampling, stratified random sampling, cluster sampling, multiphase sampling, and multistage sampling. It also discusses some non-probability sampling techniques like quota sampling and purposive sampling.
Uploaded by
Vijay ChinthaCopyright
© © All Rights Reserved
We take content rights seriously. If you suspect this is your content, claim it here.
Available Formats
Download as PPTX, PDF, TXT or read online on Scribd
/ 62